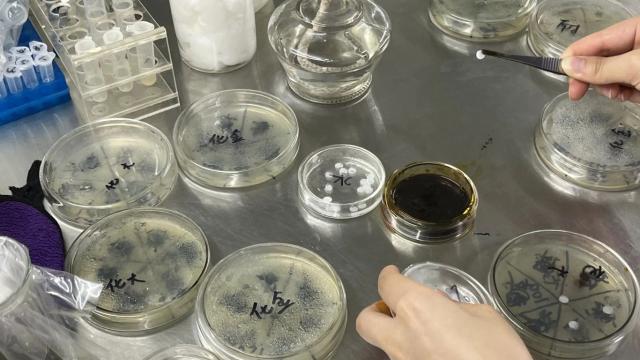

双十一大促!这个民大校园好货你确定不加购买?
那是中南民族大学的第一名 3471 条推送
一年一度的“双十一”狂欢节
我们“卷起来”
准备好和民哥南妹一起准备
升级快乐门槛嘛!
不需要邀请朋友,不需要找群,不需要满减,
这些专属民大学生的校园好货
让每个人都好玩又好逛


SALE
卷王学习卡
轻轻地走进门,是一片安静的一片。
南北书院桌椅整齐,灯光温和
各种书籍在双子塔里错落有致。
讲述不同的故事
这所学校最安静的角落
然而,最活跃的思维却在涌动。
它保留了文明的火种
还可以滋养未来的知识
翻动手指页面
笔划过纸面
刺激淡淡的纸墨香味
那就是思维烘焙知识的味道。
键盘碰撞的声音偶尔会传来
或者有纸笔摩擦的声音
那是未来扎根发芽的声音。



HOT.11.11
淘密码:努力工作
SALE
社团感受票
理想如光,引领方向
人民代表大会为我们提供追梦的舞台。
有着共同的梦想
我们聚集在一起
向光前进,追光而去
青春的悸动在心中激荡
每个人都在自己的领域里用心追求梦想。
见证活力在音符中飞翔。
任意泼墨铸就激情章节
期待喜欢从这里扬帆远航。



HOT.11.11
淘密码:一份爱
SALE
共享健身房
感受运动中生命的力量。
让青春在奔跑中闪耀
南湖操场
从早到晚
充满汗水的挥洒
青春的脉搏在这里跳动
自由的风在这里鼓掌
每一个飞奔、跳跃的瞬间
对健康和青春的赞美是一种赞美。
每一滴汗水,眼泪都会滴落。
向困难和努力致敬。
这个节奏属于民大
又是民大人对生活的热情拥抱。




HOT.11.11
淘密码:一些运动
SALE
志愿活动证
我们和世界
在每一个全新的日子里相遇。
追寻光明,沐光前行
让善意降落在一颗颗厚厚的心中。
深言深语,我们浅浅地说。
路漫漫其修远兮,我们慢慢地
为了吸引日光而生长的花蕾
为琐碎的生活积累温暖。
心流淌善意
爱在四季
她们乐此不疲,追求爱与永恒。
用行动编织美丽的校园
我常常警告自己
注意幸福
就像在寒冷的日子里经常看太阳一样。
心灵不自觉地暖洋洋,光芒四射。




淘密码:一颗爱
SALE
课堂参与券
学生们不停地笑,老师们妙语连珠。
在民大的课堂上
教师不再是无聊的讲师。
这是故事的引领者
问题就像接力棒一样在学生之间传递。
答案总是充满意想不到的惊喜。
游戏与知识相结合,轻松自在
这里不再是刻板的知识传递场所。
这是思想的碰撞和交流的圣殿。
每一个人都踊跃发言
整个教室似乎都活了起来。
在如此欢快的气氛中,知识完成了传递

HOT.11.11
淘密码:一点热情
SALE
美景大会员
感知快乐是一种能力
星空比我们想象的要好
更加广阔,更加浩瀚
夕阳比我们的眼睛更亮
更加明亮和纯净
枯叶铺路 秋风微凉
阳光温柔 南湖如镜
我们是岩层
我们是橡树
并排生长在荒野中
夕阳使天空陶醉
云被晚风压碎了
你们看,南湖正在亲吻碧空
波浪互相拥抱
大自然的画笔勾勒出民大的学校生活。
留下五颜六色的样子
风景常在,幸福就在身边。




淘密码:一点小心
民大校园里充满了温度
学习,理想,健康,善良和幸福
青春的画卷交织在一起
校园里那些不贵但意义深长的“好货”
或许只是生活的点点滴滴
但是却把我们的大学时光装饰得无比丰富。
追寻梦想的路上
愿你我都能感受到这些平凡中的温暖与美好。





本文仅代表作者观点,版权归原创者所有,如需转载请在文中注明来源及作者名字。
免责声明:本文系转载编辑文章,仅作分享之用。如分享内容、图片侵犯到您的版权或非授权发布,请及时与我们联系进行审核处理或删除,您可以发送材料至邮箱:service@tojoy.com


